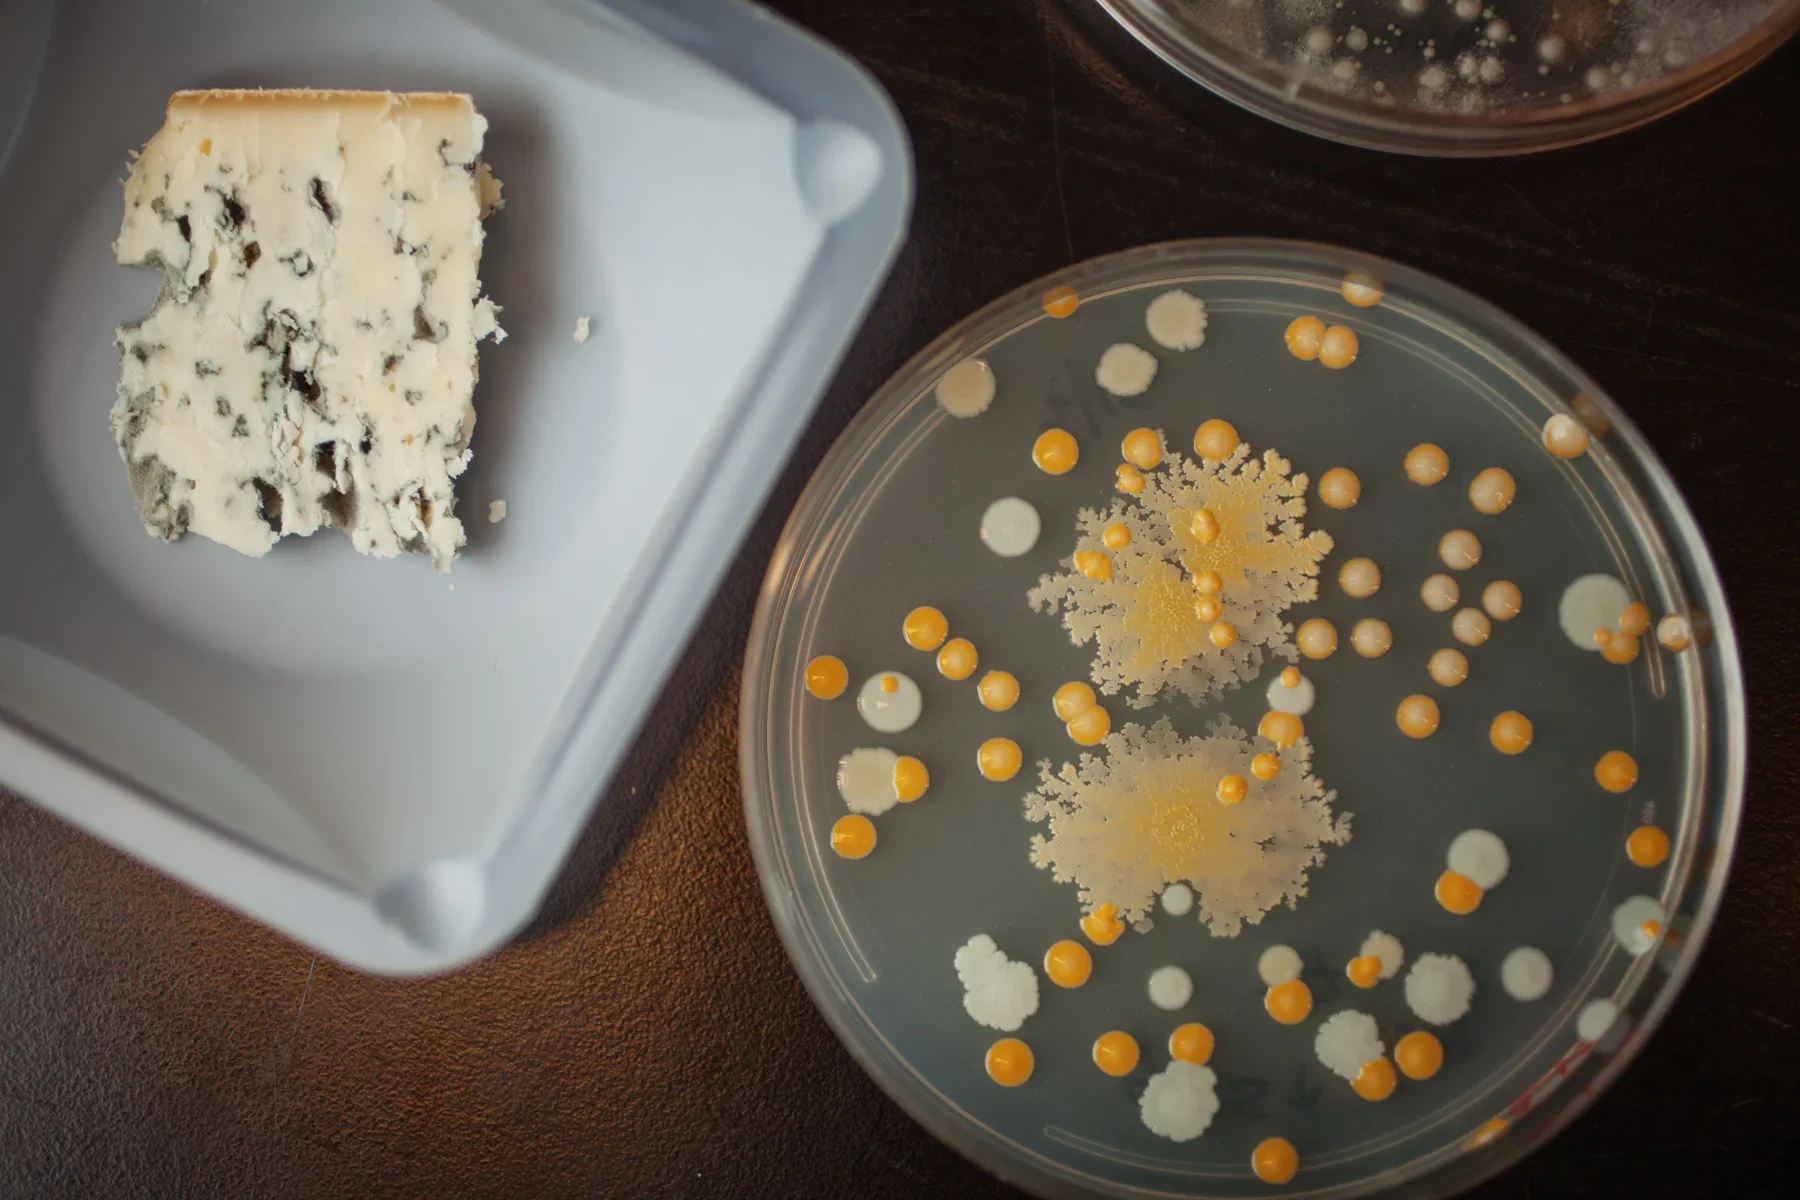
bacteria-cheese-biology-1+(1).jpg.webp

Culinary
"First we eat, then we do everything else." — M.F.K. Fisher



























"First we eat, then we do everything else." — M.F.K. Fisher